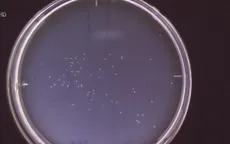

ngăn ngừa ung thư

6 mẹo ăn uống và tập thể dục đơn giản có thể giảm nguy cơ ung thư
bangdatally.xyz - Càng mang nhiều mỡ trong cơ thể, nguy cơ mắc bệnh ung thư càng cao. Theo các chuyên gia, bạn càng hoạt động thể chất nhiều thì bạn càng ít có khả năng mắc bệnh ung thư.

7 lời khuyên về lối sống giúp giảm nguy cơ ung thư
bangdatally.xyz - Trong khi một số bệnh ung thư hình thành do các yếu tố nằm ngoài tầm kiểm soát của chúng ta, một số lựa chọn lối sống có thể giúp giảm nguy cơ ung thư.

Người từ 60 tuổi không nên bắt đầu uống aspirin hàng ngày để ngăn ngừa bệnh tim mạch, đột quỵ
bangdatally.xyz - Lực lượng Đặc nhiệm Dịch vụ Dự phòng Hoa Kỳ đang xem xét thực hiện một số thay đổi đối với hướng dẫn dùng aspirin hàng ngày để ngăn ngừa bệnh tim và đột quỵ.

8 lợi ích sức khỏe không ngờ của trái khế
bangdatally.xyz - Khế thường có vị ngọt hoặc chua, là loại trái cây quen thuộc với mọi người nhưng không phải ai cũng biết loại trái cây dân dã này lại có rất nhiều lợi ích cho sức khỏe.
Dùng giun tròn để phát hiện sớm ung thư
bangdatally.xyz - Các nhà nghiên cứu Nhật Bản đang phát triển phương pháp giúp phát hiện sớm ung thư nhờ sử dụng giun tròn.

8 siêu thực phẩm ngăn ngừa ung thư tốt hơn thuốc
bangdatally.xyz - Các chuyên gia Đông y cho biết, bổ sung nghệ, gấc, tỏi, chanh, trà xanh... vào bữa ăn hàng ngày có thể giúp bạn phòng chống các căn bệnh ung thư hiệu quả.